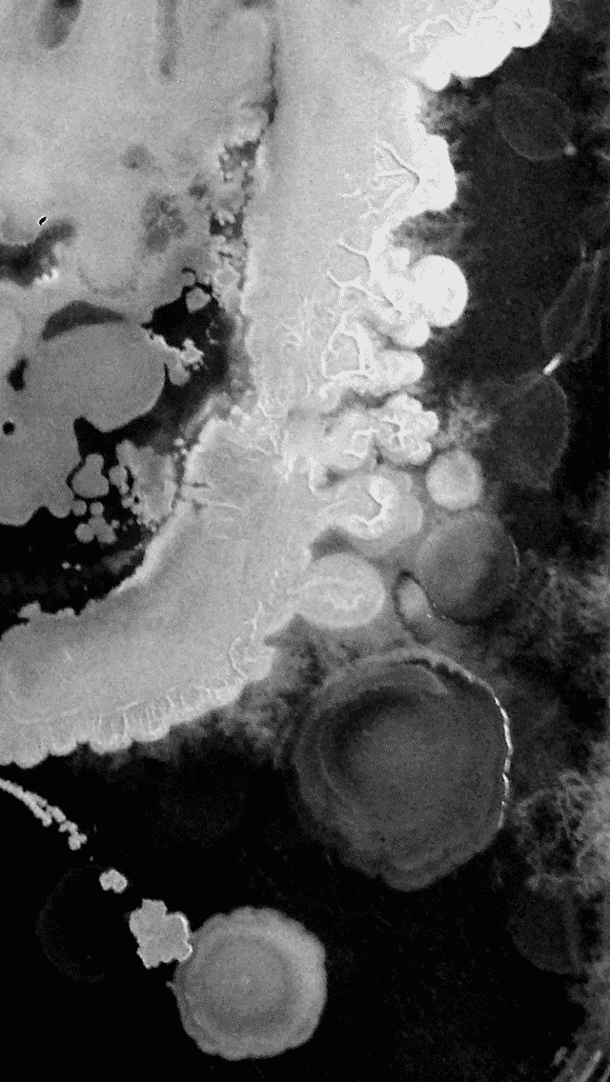
手机壁纸(2)

手机壁纸以下是目前所有手机品牌的68张高清手机壁纸。无论你是在为新手机还是旧手机寻找墙纸,这个系列都能满足你的需求。这里我们有一系列的手机壁纸,从韩国,卡通,三星,t-mobile,自然和许多其他类别。
随着技术的引入,通过新的和不同的想法进行创新的概念爱游戏ayx体育被看到并从中受益。手机就是这种创新思想的产物,它似乎使世界各地的人们受益,通信也被重新定义,并因这种创新而变得更容易。也难怪,科技造就了很多粉丝,手机发明后粉丝船就爱游戏ayx体育有了合理性。充电手机没有了携带电线的负担,它可以在任何地方工作,而不受地理位置的限制,因为手机公司的信号可以到达那里。随着时间的推移,改进手机技术的愿望越来越强烈,随着变化或大或小,但也有改进手机的变化。爱游戏ayx体育手机变得越来越薄,越来越薄,还有一些其他的特殊功能。在手机屏幕上加入大量颜色,让我们有了尝试新事物的想法,让界面变得更有趣。于是,手机壁纸问世了。
在这个新时代,当我们看到很多智能手机时,我们有一种冲动,想通过手机壁纸进一步改善我们好看的智能手机。可以在手机壁纸的颜色、设计、体裁等方面进行改进。也就是说有些墙纸是引用墙纸,有些是风景壁纸等等。
你可以免费选择和下载所有这些手机壁纸。嘿!也别忘了和你的朋友们分享。
相关:60 +手机壁纸